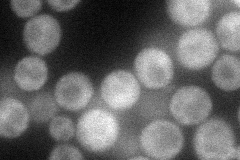
YJL005W
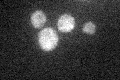
YJL005W

View description
Adenylate cyclase, required for cAMP production and cAMP-dependent protein kinase signaling; the cAMP pathway controls a variety of cellular processes, including metabolism, cell cycle, stress response, stationary phase, and sporulation
Localization:
Intensity:
Fold change:
Significance:
-
C’ GFP library in SD

cytosol25.09 -
N' NOP1pr-GFP in SD
cytosol45.9729 -
N' TEF2pr-mCherry in SD

cytosol56.65 -
N' NATIVEpr-GFP in SD

cytosol26.2939 -
N' TEF2pr-VC and Cyto-VN in SD

cytosol41.8374 -
C’ GFP library in SD+DTT

cytosolN/AN/ANo -
C’ GFP library in SD+H2O2

cytosolN/AN/ANo -
C’ GFP library in Starvation Media
cytosolN/AN/AYes -
C’ GFP library on the background of Pup2-DaMP

cytosol -
C’ GFP library on the background of CCT mutant

cytosolN/AN/ANo
